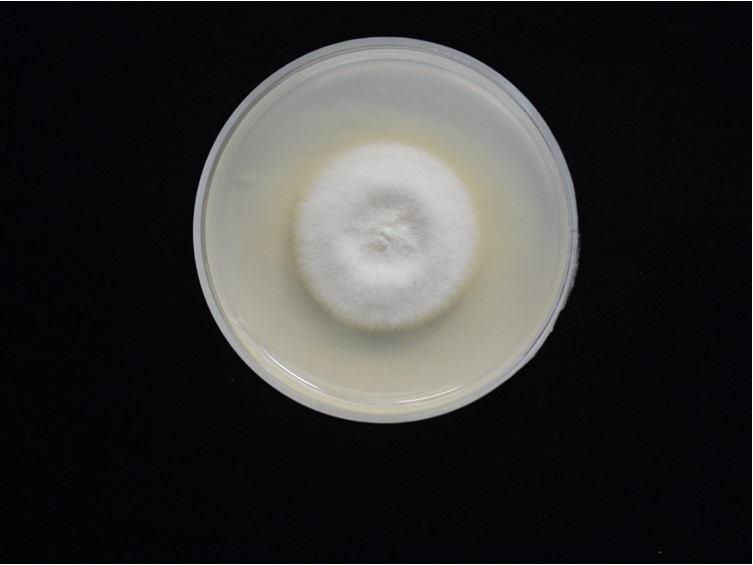

Holotype:
THAILAND, Chiang Mai Province, Doi Inthanon National Park, 29 Oct. 2013, K. Tasanathai, P. Srikitikulchai, A. Khonsanit; W. Noisripoom, D. Thanakitpipattana, S. Watcharapayungkit, holotype BBH 37826, ex-type living culture BCC 68502.
Habitat:
Buried in soil.
Host:
Coleopteran larva.
Description:
 Stromata solitary or multiple, unbranched, 10-35 mm long and 1 mm broad, pale orange, cylindrical. Rhizoids flexuous, arising from the head region of coleopteran larvae buried in soil, 18-25 mm deep under the ground. Fertile part yellow orange, cylindrical to clavate, 2-5 mm long, 1-2 mm broad, occasionally lateral on stroma.
Stromata solitary or multiple, unbranched, 10-35 mm long and 1 mm broad, pale orange, cylindrical. Rhizoids flexuous, arising from the head region of coleopteran larvae buried in soil, 18-25 mm deep under the ground. Fertile part yellow orange, cylindrical to clavate, 2-5 mm long, 1-2 mm broad, occasionally lateral on stroma.  Perithecia semi-immersed, narrowly ovoid, 300-350 × 120-180.
Perithecia semi-immersed, narrowly ovoid, 300-350 × 120-180.  Asci cylindrical, eight-spored, up to 220 × 4-5 μm, with cap 2-3 μm thick.
Asci cylindrical, eight-spored, up to 220 × 4-5 μm, with cap 2-3 μm thick.  Ascospores hyaline, filiform, multi-septate, 125-180 × 1-1.5 μm. Anamorph: Two types of conidial arrangement: acremonium-like, conidia aggregated in heads at the apex of phialides; mariannaea-like, conidia in imbricate chains, connected to each other laterally.
Ascospores hyaline, filiform, multi-septate, 125-180 × 1-1.5 μm. Anamorph: Two types of conidial arrangement: acremonium-like, conidia aggregated in heads at the apex of phialides; mariannaea-like, conidia in imbricate chains, connected to each other laterally.
Culture characteristics:
Colony on PDA attaining a diam of 30 mm in 10 d, cottony with high mycelium density, white, powdery after 21 d. Phialides arising from aerial hyphae, solitary or in whorls of two to five on each branch, gradually tapering from the base to the apex, 5–15 × 1–2 μm. Conidia hyaline, oblong-elliptical or ellipsoidal, smooth, one-celled, 2–5 × 1.5–2 μm.
Colony on PDA attaining a diam of 30 mm in 10 d, cottony with high mycelium density, white, powdery after 21 d. Phialides arising from aerial hyphae, solitary or in whorls of two to five on each branch, gradually tapering from the base to the apex, 5–15 × 1–2 μm. Conidia hyaline, oblong-elliptical or ellipsoidal, smooth, one-celled, 2–5 × 1.5–2 μm.
Reference:
Mongkolsamrit S, Noisripoom W, Tasanathai K, et al. (2020). Molecular phylogeny and morphology reveal cryptic species in Blackwellomyces and Cordyceps (Cordycipitaceae) from Thailand. Mycological Progress 19: 957–983.
DOI: https://doi.org/10.1007/s11557-020-01615-2Species |
Strain |
Compound |
Pubchem CID |
Biological activity |
Reference |
|---|
|
Strain |
ITS | LSU | RPB1 | RPB2 | TEF1 |
|---|---|---|---|---|---|
| BCC 68500 | MT000694 | MT003030 | MT017802 | MT017821 | MT017842 |
| BCC 68502 | MT000695 | MT003031 | MT017803 | MT017822 | MT017843 |